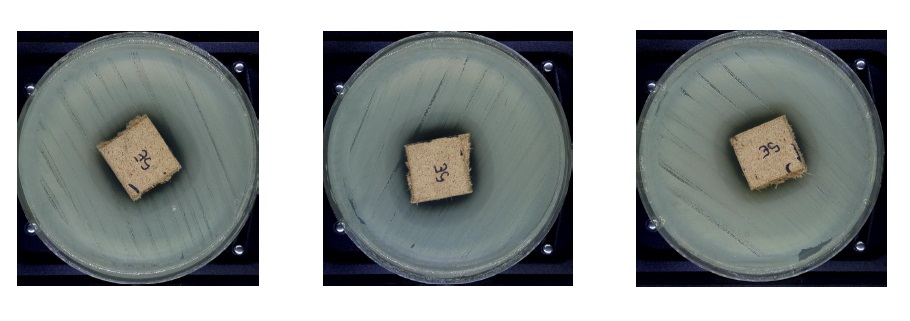

Microbiology Lab affirms the efficacy of Oxygen as an antibacterial coating
McMasters Center for Microbial and Chemical Biology (CMCB) at the Michael G. DeGroote Institute for Infectious disease center affirms that after carrying out tests in accordance with the Kirby-Bauer halo and ISO 22196, Oxygen coating has antibacterial capabilities. When the lab tests were carried out in two time lines and on three sets of sample surfaces it was evident that the halo effect (or immunity shield) around the coated area showed no signs of bacteria penetration (99% kill rate) or growth while the control samples did not offer any bacterial protection as evidence of Oxygen coatings effectiveness.
In simple terms, this means that upon contact with any oxygenated surface, bacteria that can cause serious damage to human respiratory system is killed within minutes.

The pathogens used included Staphylococcus aureus (S. aureus, Gram-positive).
These bacteria commonly inhabit the skin and nose but may enter the body through cuts or abrasions and or through respiratory inhalation which may be nearly invisible to see. Once inside the body, the bacterium may spread to a number of body systems and organs, including the heart, where the toxins produced by the bacterium may cause cardiac arrest. Once the bacterium has been identified as the cause of the illness, treatment is often in the form of antibiotics and, where possible, drainage of the infected area. However, many strains of this bacterium have become antibiotic resistant; for those suffering these kinds of infection, the body’s own immune system is the only defense against the disease. If that system is weakened or compromised, the disease may progress rapidly.[1] Anyone can contract Staph, but pregnant women, children, and people with chronic diseases or who are immuno-deficient are often more susceptible to contracting an infection.